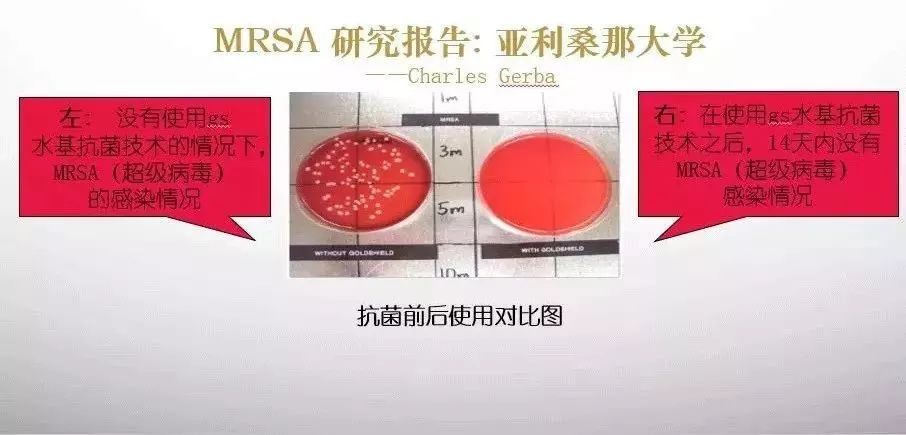
城市规划需配有地下空间规划‘ky com’(图4)

咨询热线
0452-64325281
地址:江苏省淮安市廉江市李心大楼61号
手机:13465620382
邮箱:admin@hzjianghehuhai.com
手机:13465620382
邮箱:admin@hzjianghehuhai.com
城市规划需配有地下空间规划‘ky com’
发布时间:2026-02-20 08:20:04 点击量:
本文摘要:该办法特别强调的是,在城市总体规划的基础上不应编成地下空间开发利用专项规划,规划期限与城市总体规划致…“地下空间开发利用专项规划应该实施城市总体规划和土地利用总体规划关于地下空间开发利用的强制性规定,并与人民防空工程规划以及各专项规划互为协商…城市规划须要备有地下空间规划“今后编成城市规划须要制订设施的地下空间开发利用专项规划!”为强化对佛山地下空间开发利用的管理,合理开发利用地下空间资源,增进土地节约集约利用,佛山规划部门专门制订了《佛山市地下空间开发利用管理暂行办法》(以下全称“暂行办法”),并从即日起至本月6日,向公众展开公开发表征询意见。
该办法特别强调的是,在城市总体规划的基础上不应编成地下空间开发利用专项规划,规划期限与城市总体规划致…“地下空间开发利用专项规划应该实施城市总体规划和土地利用总体规划关于地下空间开发利用的强制性规定,并与人民防空工程规划以及各专项规划互为协商…城市规划须要备有地下空间规划“今后编成城市规划须要制订设施的地下空间开发利用专项规划!”为强化对佛山地下空间开发利用的管理,合理开发利用地下空间资源,增进土地节约集约利用,佛山规划部门专门制订了《佛山市地下空间开发利用管理暂行办法》(以下全称“暂行办法”),并从即日起至本月6日,向公众展开公开发表征询意见。 暂行办法总则中首先具体,该办法限于于佛山行政区域范围内地下空间开发利用和管理。“本办法所称之为地下空间是指地表以下的空间,明确还包括结建地下工程和单建地下工程。

” 暂行办法专门提及,地下空间的研发、利用和管理应该遵循维护资源、规划专责、综合开发、合理利用的原则。 该办法特别强调的是,在城市总体规划的基础上不应编成地下空间开发利用专项规划,规划期限与城市总体规划完全一致。“地下空间开发利用专项规划应该实施城市总体规划和土地利用总体规划关于地下空间开发利用的强制性规定,并与人民防空工程规划以及各专项规划互为协商。” 办法同时拒绝各级政府在编成城市控制性详尽规划时,应该实施地下空间开发利用专项规划的强制性拒绝,其中重点地段的城市控制性详尽规划应该根据地下空间详尽规划拒绝对城市地下空间开发利用作出明确规定。

本文关键词:kycom,ky.com,ky com
本文来源:kycom-www.hzjianghehuhai.com

